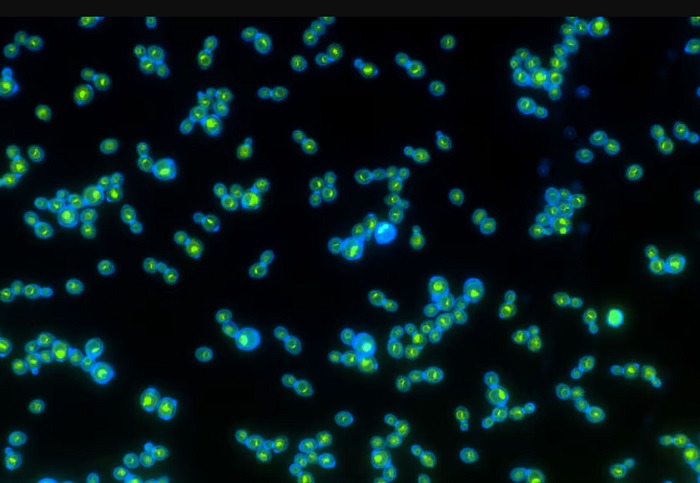

Bước đột phá trong quá trình sinh tổng hợp thuốc điều trị ung thư Paclitaxel (27/01/2024)
Paclitaxel là một loại dược phẩm chống lại khối u tự nhiên
có cấu trúc phân tử đặc biệt phức tạp và độc đáo, được dùng rộng rãi trong điều
trị lâm sàng ung thư vú, ung thư buồng trứng, ung thư phổi.

Phát triển vật liệu pin lithium mới dành cho xe điện thân thiện với môi trường (26/01/2024)
Với sự phát triển của xe điện trong thời kỳ biến đổi khí hậu,
các nhà khoa học đang nỗ lực phát triển các loại pin bền vững hơn để ngăn chặn
lãng phí quá mức gây ảnh hưởng đến môi trường.

In 3D đồ nội thất trong vài phút bằng kim loại lỏng (26/01/2024)
Nhóm chuyên gia MIT phát triển công nghệ in 3D nhanh gấp 10
lần các quy trình in 3D kim loại tương tự, dù vẫn hạn chế về thẩm mỹ.

Đột phá về công nghệ - Pin thể rắn cho khả năng sạc đầy trong 10 phút (23/01/2024)
Các nhà nghiên cứu từ Trường Kỹ thuật và Khoa học Ứng dụng
John A. Paulson (SEAS) của Harvard đã phát triển một loại pin thể rắn có thể sạc
và xả ít nhất 6.000 lần và có thể được sạc lại trong khoảng thời gian ngắn.

Phát triển miếng dán da được điều khiển bằng điện thoại thông minh cung cấp nhiều loại thuốc theo yêu cầu (21/01/2024)
Một miếng dán mới có thể đeo được có thể giúp ích bằng cách
truyền các loại thuốc khác nhau qua da một cách không đau đớn khi được kích hoạt
bởi điện thoại thông minh.

Nhà máy đầu tiên kết hợp thu giữ carbon và lọc nước mặn (19/01/2024)
Nhà máy tích hợp giúp loại bỏ 50.000 tấn CO2 mỗi năm, đồng
thời sản xuất nước ngọt từ nước mặn sẽ được xây tại khu công nghiệp Daesan.

Hệ thống sạc xe điện không dây 500 kW siêu nhanh (18/01/2024)
Hệ thống mới do công ty Mỹ phát triển được lắp đặt dưới mặt
đường, có thể sạc đầy pin cho xe tải điện hạng nặng chỉ trong 15 phút.

Phát triển pin nhiên liệu vi sinh lấy năng lượng hoàn toàn bằng đất (18/01/2024)
Một nhóm nghiên cứu của Đại học Northwestern đã chứng minh
phương pháp mới đáng chú ý để tạo ra điện, với thiết bị có kích thước bằng bìa
mềm đặt trong đất và thu năng lượng được tạo ra khi vi khuẩn phân hủy chất bẩn.
Phương pháp điều trị hiệu quả đầu tiên cho bệnh ung thư tuyến tiền liệt (17/01/2024)
Các nhà khoa học tại Đại học Nottingham Trent ở Anh muốn
nghiên cứu các đặc tính chống ung thư của Carnosine chống lại tế bào có nguồn gốc
từ cả ung thư tuyến tiền liệt nguyên phát và di căn; nơi ung thư bắt đầu và nơi
nó đã lan sang một bộ phận khác của cơ thể.
Công nghệ mới tạo ra nấm men chạy bằng năng lượng mặt trời (17/01/2024)
Các nhà khoa học đã tạo ra công nghệ mới có thể tạo ra nấm
men bằng cách thu năng lượng từ mặt trời. Nhóm nghiên cứu cho biết, kỹ thuật
này cực kỳ dễ thực hiện, không chỉ giúp hiểu thêm về sự tiến hóa mà còn tạo ra
bia và nhiên liệu sinh học tốt hơn.